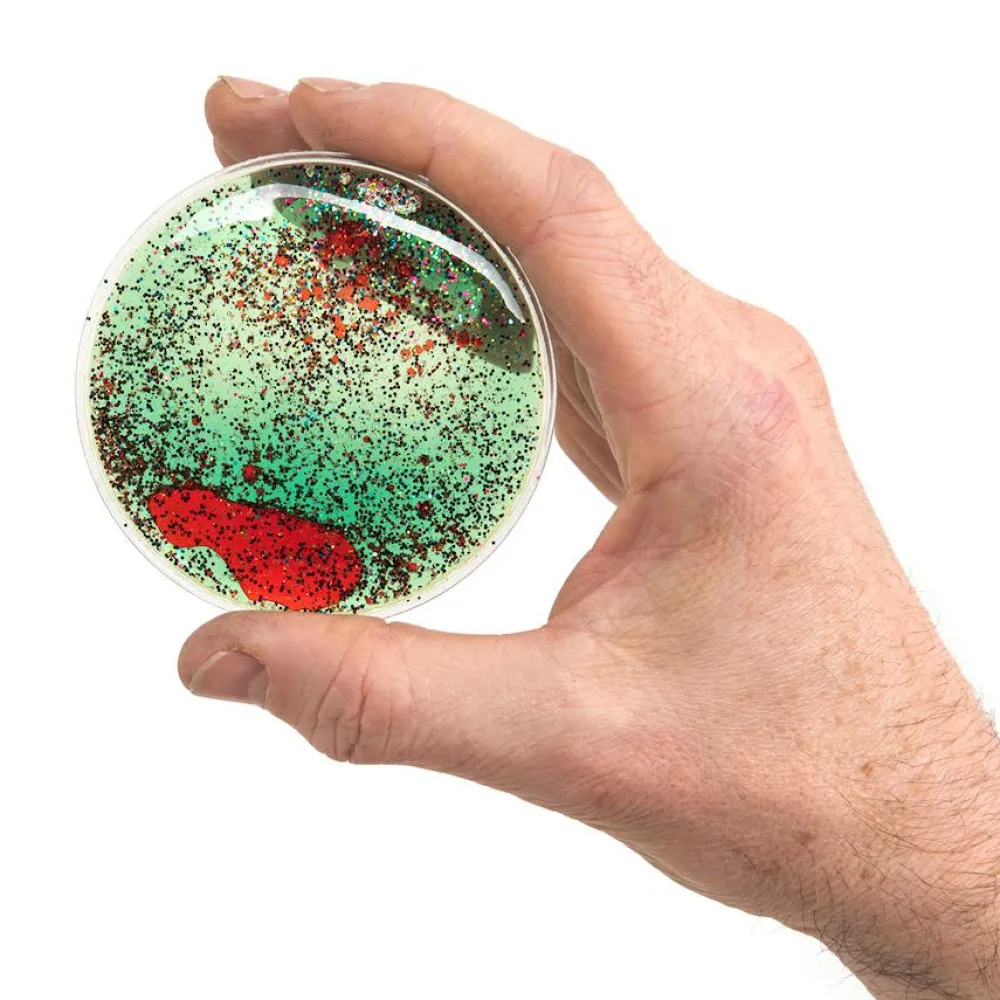

- Understøtter indlæringen hos dit barn. Du kan stimulere dit barns indlæring med både opgavehæfter, byggeleg og når dit barn har gang i sin krop.
- Giver en dejlig ro og pause på en ellers begivenhedsrig dag.
8 cm. i diameter er disse smukke, fyldte skiver med væske og glimmer indeni.
Skiverne er gode som taktil sansestimulering til børn med vanskeligheder. De kan mases, bøjes, presses, og dit barn kan forsøge at fange boblerne og glimmeret indeni.
Skiverne er diskrete og kan bruges i større forsamlinger, mens dit barn fx er i en læringssituation og har brug for noget mellem fingrene til at give jordforbindelse (grounding) og ro.
Skiverne er oplagte til at bruge sammen med eksempelvis en lyskasse eller et lysbord, som vi også har i sortimentet her i webshoppen.
Lavet af plast og indeholder vand eller fødevaregodkendte olier tilsat farve og konservering. De er testet og lever til europæiske standardkrav. De må ikke punkteres, klippes eller skæres i og bør ikke trampes på.
Aktiviteten udvikler kompetencer og er herlig for dit barns trivsel:
- Giver mulighed for fordybelse og afslapning for dit barn.
- Styrker dit barns indlæring, som sættes i gang af både faglig læring, og når dit barn bruger sin krop.
- Udvikler og forbedrer dit barns koncentration hos dit barn.
Velegnet til børn i alderen fra 3 år.
Før gumlede man på sit ærme, tegnede kruseduller eller klikkede med kuglepennen, når man ikke kunne koncentrere sig og havde uro i kroppen. I dag nulrer børn og voksne med fidget toys eller dimseting, som de også kaldes.
Nogle gange forstyrrer demere, end de giver ro. Det kommer en del an påsituationen og det enkelte barns behov for stimulering af sanserne . Derfor er det ikke et quick fix at give dit barn en tyggehalskæde, en squishy eller en tangle at dimse med, hvis det er svært for dit barn at sidde stille. Tag altid dit barns behov for noget at gumle på eller have i hænderne alvorligt og find ud af, hvad der hjælper bedst.
DU kan også sagtens give dit barn dimseting og fidgets til tidsfordriv for sjov.
| Alder | 3 år, 4 år, 5 år, 6 år, 7 år, 8 år, 9 år, 10 år, 11 år, 12 år, 13 år, 14+ år |
|---|---|
| Velegnet til | Fordybelse og afslapning, Indlæring, Koncentration |
| Funktion | Finmotorik, Fordybelse og afslapning, Hånd-øje-koordination, Koncentration, Tålmodighed |
| Materiale | Plast |

Reviews
There are no reviews yet.